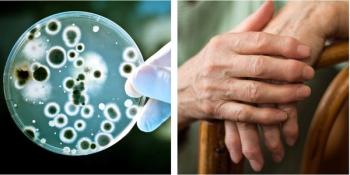
Glucocorticoids and Biologics Share Similar Infection Risk in Rheumatoid Arthritis

Articles by Ingrid Torjesen

“Based on 16,235 pairs of zoledronic acid and denosumab initiators (for osteoporosis), we found a greater risk (HR 1.25, 95% CI 1.04-1.50) of atrial fibrillation with zoledronic acid vs denosumab: an absolute risk difference of 3.69 events per 1000 person-years,” said Seoyoung Kim, MD, ScD.

Dr Joan Lo, MD, a research scientist with the Kaiser Permanente Northern California Division of Research, said: “We found that hip fracture risk in women did not differ if women stopped bisphosphonate use after five years or stayed on the medication for 10 years. Whether there is a benefit to staying on the drug for seven years needs to be further studied in randomized trials.”

A range of biologic therapies are available as options for treating patients with rheumatoid arthritis who do not respond to first-line conventional DMARDs, but which to choose and why? Test your knowledge of biologics with this quiz.

“The most important take home message for rheumatologists is that we can predict lack of response to methotrexate by analyzing the fecal microbiome of patients before the initiation of the treatment,” said Jose Scher, MD, rheumatologist from the Department of Medicine, Mount Sinai School of Medicine, New York.

The study is the first randomized trial to examine the comparative benefits and safety of biological drugs with different modes of action versus active conventional treatment.

“Bone mineral density screening rates remain low, as do calcium/vitamin D supplementation and primary prophylaxis with anti-osteoporotic therapy," lead author Eileen Rife, MD, said.

The results of a study presented at ACR 2020 demonstrate that a greater proportion of patients were initiated on denosumab compared with bisphosphonates for the first time—18.5% compared with 16.9%— in 2018.

Some of the latest developments in the use of these diagnostic tools for psoriatic arthritis were presented the annual meeting of the American College of Rheumatology Convergence 2020 in November.

“The main take home message is to pay attention to the prevention and treatment of GIOP while prescribing steroids to the patients because the side effects is steroids are not benign," Shikha Singla, MD, said.

Ixekizumab appears to provide significantly greater simultaneous joint and skin improvement for patients with psoriatic arthritis than adalimumab and doesn’t require combination with methotrexate to boost its efficacy.

Findings from a study presented at ACR 2020 showed a clear difference in co-morbidities and medication use associated with osteoporosis at different lumbar levels. Here, a Q&A with the co-author.

Young men with distal radius fracture are likely to have hormonal imbalances suggests the first study to look at sex hormone levels in younger men experiencing fractures.

Non-heterosexual minority men have a greater risk of poor bone health than heterosexual men, and this risk appears to be independent of lifestyle and psychosocial factors, suggests a study published in the American Journal of Human Biology.

Positive ACPA status may not necessarily mean a greater likelihood of osteoporosis and fracture for rheumatoid arthritis patients, study shows.
Continued use of low dose glucocorticoid in patients with rheumatoid arthritis also treated with stable DMARD therapy is associated with a small but significant risk of serious infection, show the results of a study published in Annals of Internal Medicine.

DMARDs improve vascular stiffness in patients with early rheumatoid arthritis regardless of impact on rheumatoid arthritis disease, shows new research published in the Annals of the Rheumatic Diseases.

More than half of patients with psoriatic arthritis have to wait two or more years for a diagnosis, researchers report.

Many patients with psoriatic arthritis live with unacceptable levels of disease activity despite treatment, and patient-reported outcomes could provide useful treatment targets, shows a new study.

In this Q&A, Edgar Wiebe, M.D., of Charité University Medicine Berlin, discusses the findings of a study recently presented at the American College of Rheumatology annual meeting that looked at the impact of a number of factors on bone mineral density.

Several factors can increase the risk of fractures and osteoporosis in patients with systemic sclerosis, including poor functional status and being underweight, according to researchers reporting at the annual meeting of the American College of Rheumatology on Saturday. However, the impact of proton pump inhibitors was less clear.

Non-corticosteroid immunosuppressant use and long duration of disease increase the likelihood of patients with systemic osteopenia being diagnosed with osteopenia and osteoporosis, according to researchers reporting at the annual meeting of the American College of Rheumatology on Friday.

Doctors increased their use of DEXA screening and initiate osteoporosis therapy more frequently after the implementation of an initiative to raise their awareness of the 2017 American College of Rheumatology (ACR) guidelines for the management of glucocorticoid-induced osteoporosis (GIOP), according to researchers reporting at the annual meeting of the American College of Rheumatology on Friday.

Beta blockers may slow the rate of bone loss that occurs as people age, a study published in JBMR Plus suggests.

Use of either oral or inhaled corticosteroids to manage asthma can increase the risk of osteoporosis and fragility fractures, suggest the findings of a large study published in Thorax.

Depression may be linked to an increased risk of rheumatoid arthritis, particularly patients taking antidepressants, shows a new study.

Weight fluctuation in rheumatoid arthritis patients appears to be associated with higher cardiovascular risk in patients with rheumatoid arthritis, especially if they are not overweight, shows a new study.

Patients with rheumatic disease are encouraged to participate in regular exercise to reduce the impact of symptoms, such as osteoporosis, and also to protect against the development of other chronic conditions, in particular cardiovascular disease. But which specific symptoms can be improved, and what type of exercise is recommended and how much? Test your knowledge in this quiz.

In order to achieve the best clinical outcomes in rheumatoid arthritis, experts suggest an early diagnosis is essential. Early and prompt treatment is recommended to reduce the risk of permanent joint damage. In this quiz, we test your knowledge about an early rheumatoid arthritis diagnosis.

Numbers of a new type of cell discovered in the blood of rheumatoid arthritis patients increase dramatically immediately before a flare.

The underlying pathogenesis of rheumatoid arthritis with and without autoantibodies may be different. Researchers say that "it is time to formally subdivide RA into type 1 (with autoantibodies) and type 2 (without autoantibodies)."